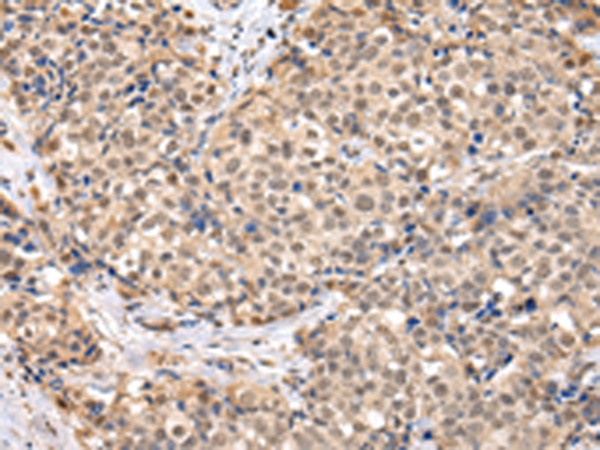

-
分类: 科研抗体货号: P01830别名: Mvp1应用: WB,IHC反应种属: Human, Mouse
-
分类: 科研抗体货号: P01824别名: SNO; SnoA; SnoI; SnoN应用: WB,IHC反应种属: Human, Mouse
-
分类: 科研抗体货号: P01821别名: SNAP-23; SNAP23A; SNAP23B; HsT17016应用: WB,IHC反应种属: Human, Mouse, Rat
-
分类: 科研抗体货号: P01882别名: TCFEB; BHLHE35; ALPHATFEB应用: WB反应种属: Human, Mouse
-
分类: 科研抗体货号: P01906别名: CC3; TIP30; SDR44U1应用: WB反应种属: Human, Mouse
-
分类: 科研抗体货号: P01874别名: EBI; TBL1; SMAP55应用: WB,IHC反应种属: Human, Mouse
-
分类: 科研抗体货号: P01903别名: RNF9; HERF1; RFB30应用: WB,IHC反应种属: Human
-
分类: 科研抗体货号: P01868别名: TAF2I; PRO2134; TAFII28; MGC:15243应用: WB,IHC反应种属: Human, Mouse, Rat
-
分类: 科研抗体货号: P01898别名: AFP; RNF95; ZNF173应用: WB,IHC反应种属: Human, Mouse, Rat
-
分类: 科研抗体货号: P01859别名: slp5应用: IHC反应种属: Human, Mouse, Rat

鄂公网安备42018502007531号
鄂公网安备42018502007531号

